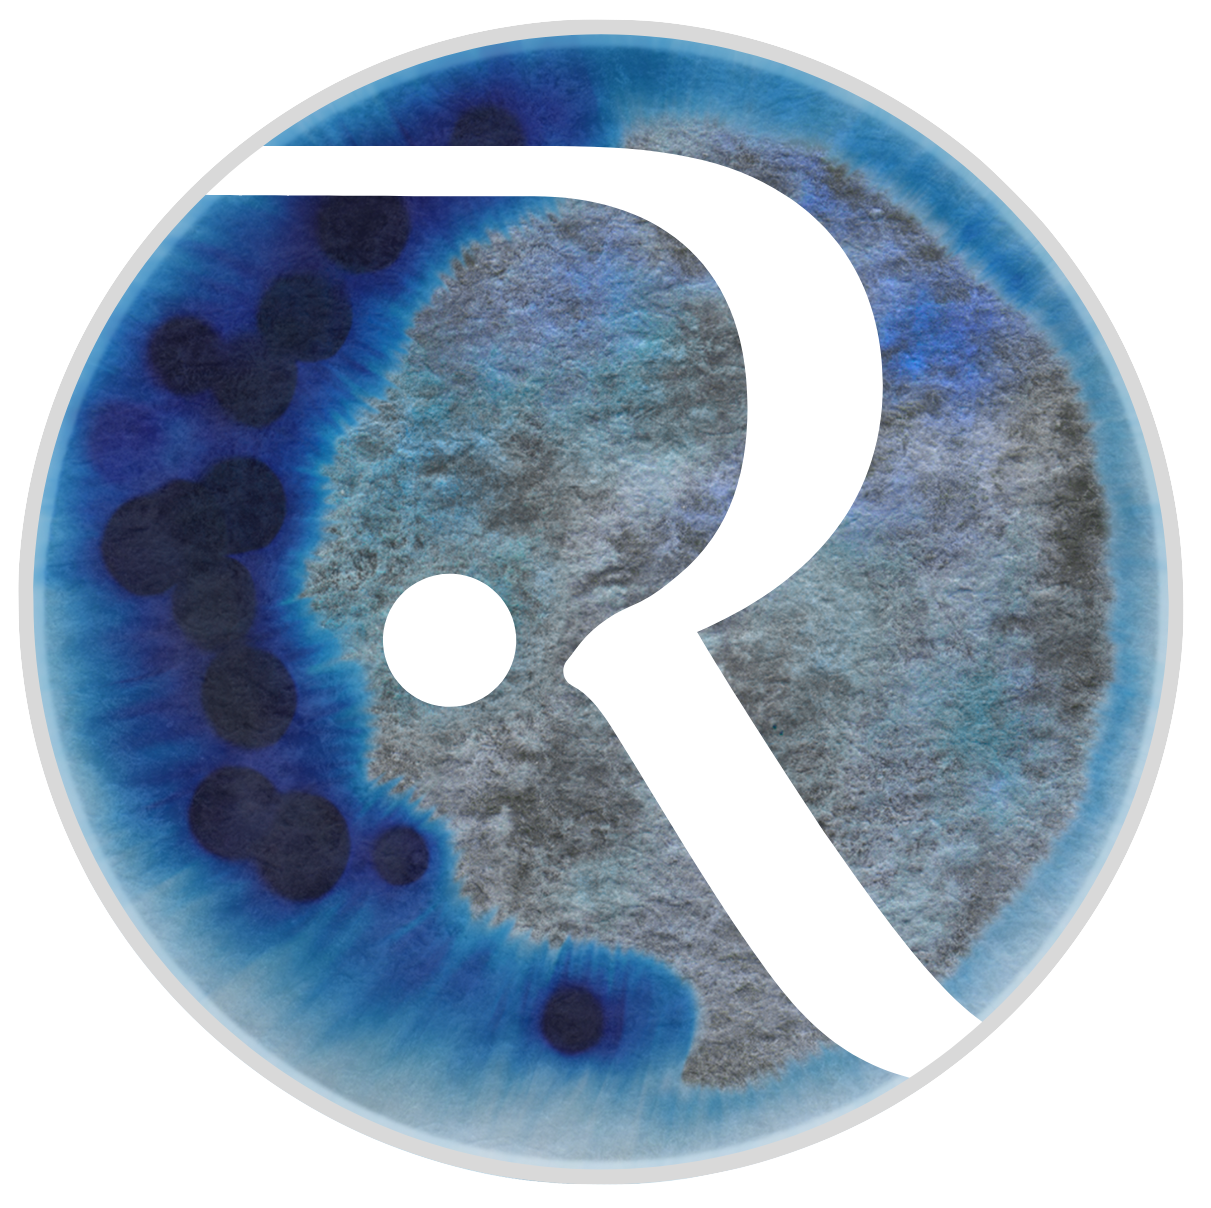
Deeply Ruuted

RUUT
THE STORY
For over two decades, Ruut has been celebrated as Baltimore’s “piano girl,” captivating audiences with her soulful, piano-driven songs. She’s collaborated with many DMV-based musicians, including DC’s Americana String Quartet, Invoke, on her fan-funded album Untold Stories.
The granddaughter of Finnish composer Aulis Sallinen, Ruut’s journey began in Eastern Europe, where she traveled with her missionary mother before moving to the U.S. Growing up in a fundamentalist church, she taught herself piano chords as the church accompanist and by writing her own songs. The organization promoted her as their prodigy, advising against pursuing music professionally outside of it.
At 23, Ruut left the sect to find her own artistic voice. Her path led her through Nashville, New York, and Los Angeles, where she built community and refined her sound. She’s shared stages with Hem, Brett Dennen, Trevor Hall, and Passenger, and performed at iconic venues including Wolf Trap, The Fillmore, The Roxy, and Hotel Café. Her songs have appeared in film, including the award-winning documentary It Happened Here, and she’s collaborated with renowned songwriters and producers such as Billy Steinberg, Jeff Trott, and Frank Wolf.
Today, Ruut channels her experience into Making Her Mark, a Baltimore-based nonprofit supporting women artists through grants and mentorship—paying forward the support of a beloved mentor who helped her rebuild her artistry and self. “Not everyone’s story is as extreme as mine,” she says. “But almost every woman artist I speak with faces some kind of barrier to being absolutely free to create.”
Ruut’s upcoming album, Motherland—a piano-based folk-pop collection reimagining ancestral stories through a modern, empowering lens—will be released in 2026 during her tour as Finlandia Foundation’s Performer of the Year. Blending Nordic vocal textures, memorable hooks, and subtle electronic yoga-inspired sounds, Motherland explores themes of longing, wildness, and the journey home. Known for performances that weave song and poetry, Ruut leaves audiences inspired and more connected to their own creativity.
Photos by E. Brady Robinson